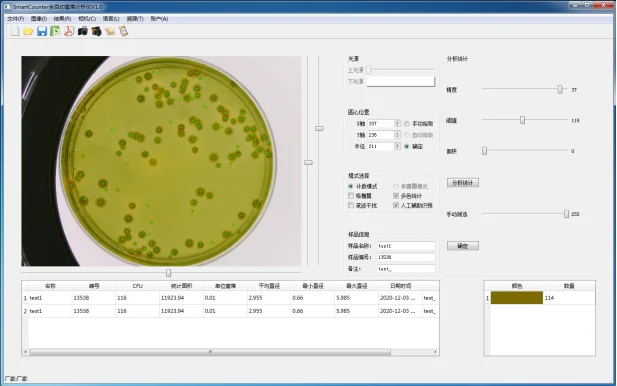
普通平板在菌落计数器显示界面

常见全自动菌落计数器介绍
发布时间:2025-12-31 浏览次数:7586
现代智能菌落计数器是一种高清摄像头拍照,自动识别的自动细菌数检验仪器。主要由上下光源,高清摄像头,智能识别系统,数据库等部分组成。目前市面上主要分以下三种:
一.具备一般性能的菌落计数器,由不可调的上下光源组成,摄像头可以满足一定的拍照清晰度等,这类的菌落计数器可以实现一般的菌落计数,精度相对较低。
图①:环凯全自动菌落计数器
二.性能稍微好一些的,在一般性能的基础上,摄像头升级为高清摄像头,添加自动识别之后可以进行人工手动补充或删除部分错误计数的功能。这类的菌落计数器已经满足了大部分的检验机构使用了,但是对于一些要求精度比较高,菌落差别比较大,需要数据可溯源的机构,这样的基本功能是不够的。
图②:普通平板在菌落计数器显示界面
三.针对以上的问题,最近在市面上出现了一种个人认为是性能很高的菌落计数器。此款菌落计数器采用4K高清摄像头,可以根据周围的环境亮度情况和培养基不同颜色等的特点,调节光源的颜色和亮暗程度以达到更好识别效果,并且具备了实验人员笔迹抗干扰功能,可以有独立的数据库保存统计数据等。

图③:纸片培养基在菌落计数器显示界面
由此,如果是医疗机构,环境监测,食品监督,生物制药,科研单位等实验室对计数要求比较高的,使用最近出来的这款菌落计数器,完全可以在减轻实验人员劳动强度的情况下,达到高精度,高质量的菌落统计,并且做到数据可溯源。

图④:结果导出

